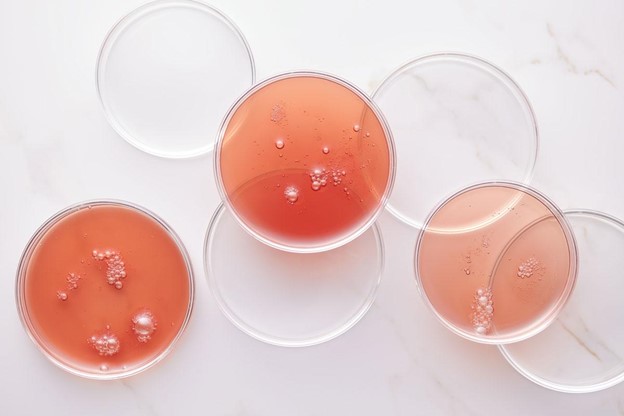
finding health supplements with bioavailability technology

2023-04-16
In today's fast-paced world, many people turn to nutritional supplements to support their health and well-being. However, not all supplements are created equal, and many fail to deliver meaningful health benefits due to poor bioavailability. Bioavailability refers to the amount of a nutrient that is absorbed and utilized by the body, and it plays a crucial role in determining the effectiveness of a supplement. We'll discuss three tips for choosing supplements with high bioavailability to ensure that you're getting the most out of your nutritional regimen. By following these tips, you can maximize your nutrient uptake and support your overall health and wellness.
Natural ingredients have several benefits over synthetic ones. First, they tend to be more bioavailable, meaning they are more easily absorbed and utilized by the body. This is because natural ingredients often contain other compounds that help with absorption, such as fiber, enzymes, or cofactors.
In addition, natural ingredients are less likely to cause side effects or adverse reactions. This is because they are recognized by the body as "real" food, rather than being seen as foreign or potentially harmful substances.
Finally, natural ingredients often have other health benefits beyond the specific nutrient they contain. For example, many plant-based ingredients contain phytonutrients, which have antioxidant and anti-inflammatory properties that can support overall health and wellness.
Some examples of natural ingredients with high bioavailability include:
These natural ingredients are easily absorbed by the body and have been shown to have numerous health benefits.

Have you ever taken a health supplement that recommended you only take it with a meal? This is because many nutrients in supplements are more easily absorbed by the body when taken with food. Some vitamins and minerals, like vitamins A, D, E, and K, are fat-soluble, meaning they are better absorbed when taken with fatty foods.
Additionally, some supplements may be irritating to the stomach, and taking them with food can help reduce the risk of gastrointestinal side effects.
But what if there were supplements that could improve bioavailability through an advanced delivery technology? At Three, we use cutting-edge advanced delivery systems in all of our supplements to ensure maximum bioavailability.
Our proprietary processes protect the active ingredients of a supplement from degradation thereby improving their absorption in the body. This allows the nutrients to be delivered directly to the cells that need them most.
This means that our supplements at Three are more efficient, effective, and bioavailable than traditional supplements.
When it comes to choosing nutritional supplements, it's important to consider where the nutrients are sourced. Some supplements may use synthetic or low-quality sources, which can negatively impact their bioavailability and effectiveness. On the other hand, supplements made from high-quality, sustainable sources can provide superior nutrition and offer a range of additional benefits.
There are a number of supplements that are sourced from ethical and sustainable sources, which can offer higher bioavailability and a range of additional health benefits. For example, Three's supplements are made using organic and sustainably sourced ingredients, such as turmeric root and ginger, which have been shown to have high levels of bioavailability.
Other examples of supplements sourced from ethical and sustainable sources include spirulina, chlorella, and marine collagen. These supplements are often produced using sustainable farming practices and are free from harmful contaminants that can negatively impact health.
In addition to providing superior nutrition, choosing supplements sourced from ethical and sustainable practices supports the health of the planet and promotes fair and ethical treatment of workers.
By choosing supplements made from organic and sustainably sourced ingredients, consumers can help support environmentally responsible farming practices, reduce the use of harmful pesticides and chemicals, and support local economies. Additionally, supporting ethical and sustainable practices can help promote fair wages and working conditions for farmers and workers involved in the production of these supplements.
Choosing supplements sourced from ethical and sustainable practices not only benefits the health of the individual but also the health of the planet and communities involved in their production.

Maximizing nutrient uptake is crucial for achieving optimal health and wellness. By choosing supplements with high bioavailability, you can ensure that your body is able to absorb and utilize the nutrients effectively.
To recap, here are the three tips for choosing supplements with high bioavailability:
By following these tips, you can make informed decisions about the supplements you choose to support your health and wellbeing. Additionally, it's important to consult with your healthcare provider before adding any new supplements to your regimen.
Incorporating high bioavailability supplements into your daily routine can be a game-changer for your health. By prioritizing nutrient absorption, you can feel confident that you're supporting your body in the best way possible. Choose wisely and here's to a happy, healthy you!
Three is a movement that is changing lives around the world by delivering greater health to PEOPLE, a dynamic PLATFORM for entrepreneurship, and greater PURPOSE through our caring community. Three exists to help people redefine what’s possible. We work tirelessly to empower lives of purpose, activate people’s potential, and create more significant lives. We rededicate ourselves every day to inspiring a world of greater health, greater wellness, and greater hope. Learn more at: iii.earth
Dr. Dan Gubler, Ph.D., Chief Scientific Officer for Three, is a Caltech-trained natural-product chemist and former professor who has traveled to every continent discovering and researching bioactive compounds in plants and using them to help others. An expert on how natural molecules from plants can dramatically improve human health, Dr. Gubler has 16 patents granted or pending and has developed 70 nutritional supplements that gross $500 million in annual sales. He holds a Ph.D. in organic chemistry from Colorado State University as well as a B.Sc. in biochemistry from Brigham Young University. Meet the rest of our advisors: click here.